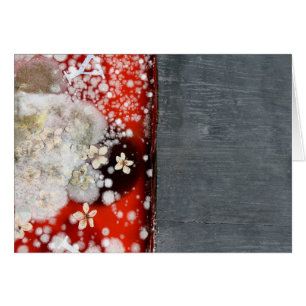
Immortality 2

Popular Painful Postcards
Popular Painful Postcards
757 results
Crafts & Party Supplies
Home & Living
Invitations & Stationery
Anniversary Cards
Baby & Pregnancy Invitations
Birthday Cards
Birthday Invitations
Cards
Christmas Cards
Christmas Party Invitations
Congratulations Cards
Enclosure Cards
Get Well Cards
Graduation Cards
Graduation Invitations
Halloween Cards
Invitations & Announcements
Mother's Day Cards
Note Cards
Postcards
RSVP Cards
Save the Dates
Seasonal Cards
Sweet 16 Invitations
Sympathy Cards
Thank You Cards
Thanksgiving Cards
Valentine's Day Cards
Office & School
Wall Art & Décor
Weddings
Postcard Torres del Paine, Patagonia
Price$3.35
Pink Rose Gold Pain Makeup Eye Glitter 16th Bridal Invitation
Sale Price $3.00. Original Price $4.00.
Water Lilies, Fine Art Oil Painting, Claude Monet Thank You Card
Sale Price $5.40. Original Price $7.20.
Holy Family towers in Barcelona Postcard
Price$3.00
Cracked Heart
Sale Price $5.67. Original Price $6.30.
Pushkin on Beauty CC0338 Poetry
Sale Price $6.71. Original Price $7.45.
Migraine Headache Pain Awareness Card
Price$5.25
No Pain No Gain Workout Motivation Card
Price$8.70
Back Pain In This Area Funny Card
Price$8.70
Think Zebras Card
Price$10.50
No Pain No Gain Motivation Card
Price$8.70
Immortality 2
Sale Price $6.35. Original Price $7.05.
Cancer Ribbons with Sunflower Card
Price$8.15
Rememberance
Sale Price $7.61. Original Price $8.45.
Your Custom Note Card
Price$5.00
Mountain Don't
Sale Price $7.16. Original Price $7.95.
Affirmation Card for the Healing of Neck Pain
Sale Price $11.39. Original Price $12.65.
Graduation Cap,Diamonds Paint Splash Graduation Invitation
Sale Price $3.79. Original Price $5.05.
So sorry postcard
Price$3.10
Search Feedback
If you need help or have a question for Customer Service, please visit our Help Centre
Recently Viewed Items